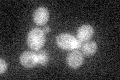
YHR115C
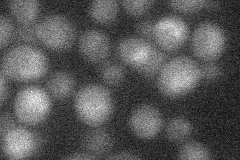
YHR115C

View description
Protein involved in ubiquitin ligation; plays a role in regulating spindle position and orientation; functionally redundant with Dma2p; orthologous to human RNF8 protein, also has sequence similarity to human Chfr.
Localization:
Intensity:
Fold change:
Significance:
-
C’ GFP library in SD
cytosol21.07 -
N' NOP1pr-GFP in SD

cytosol34.6049 -
N' TEF2pr-mCherry in SD
below threshold11.0671 -
N' NATIVEpr-GFP in SD

cytosol20.1972 -
N' TEF2pr-VC and Cyto-VN in SD

below threshold23.2815 -
C’ GFP library in SD+DTT

cytosol20.510.97No -
C’ GFP library in SD+H2O2

cytosol24.211.14No -
C’ GFP library in Starvation Media

cytosol19.020.9No -
C’ GFP library on the background of Pup2-DaMP

cytosol -
C’ GFP library on the background of CCT mutant

cytosol23.4931.11488No
